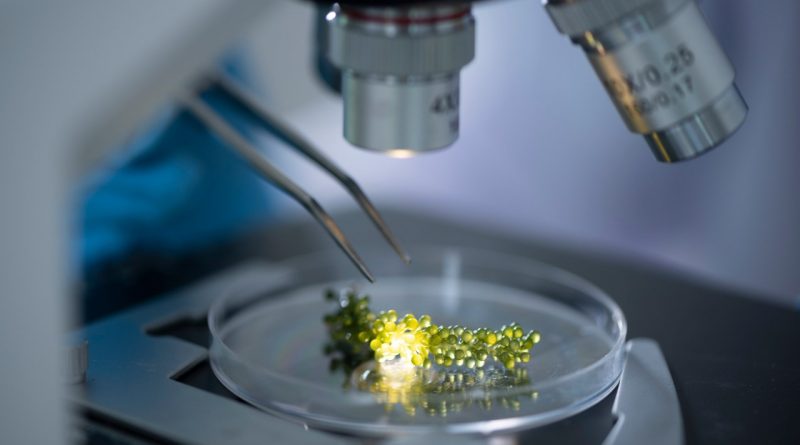

El Directorio de la Agencia Nacional de Promoción de la Investigación, el Desarrollo Tecnológico y la Innovación (Agencia I+D+i), perteneciente al Ministerio de Ciencia y Tecnología, aprobó el financiamiento para 27 iniciativas de vinculación entre grupos de investigación e instituciones o empresas que plantean desafíos tecnológicos y productivos que requieren del desarrollo de soluciones científico-tecnológicas.
Sobre la adjudicación, el ministro de Ciencia, Tecnología e Innovación, Daniel Filmus, expresó: “Los resultados de esta convocatoria confirman que una prioridad muy importante para nuestro gobierno es orientar la ciencia y la tecnología para modificar la matriz productiva” y agregó: “Sin un cambio en lo que producimos, si no agregamos valor a nuestros recursos naturales, no podemos generar mejores empleos ni garantizar a cada argentino y argentina mejores condiciones de vida lejos de la pobreza”.
Articulación con el sector productivo
Por su parte, el presidente de la Agencia I+D+i, Fernando Peirano señaló: “Cada uno de estos proyectos abre un camino nuevo, ensancha el sendero hacia el desarrollo. Son proyectos innovadores, no solo porque los objetivos que se plantean, sino también porque se basan en equipos de trabajo que combinan saberes y esfuerzos de investigadores y profesionales del ámbito científico y del ámbito productivo. Así la Agencia cumple con la segunda acción de un total de tres para acelerar la recuperación del sistema de promoción a partir de la reactivación de un préstamo internacional que estuvo durante más de custro años inactivo”.
Para evaluar los proyectos participaron más de cincuenta especialistas provenientes de distintas disciplinas, tanto del sector científico como del productivo. Las iniciativas adjudicadas representan a diez provincias y son doce las instituciones públicas beneficiarias de los proyectos.
Convocatoria extraordinaria PICT Vinculación
La convocatoria PICT Orientación a la Vinculación gestionada por el Fondo Argentino Sectorial (FONARSEC), es una de las tres convocatorias extraordinarias realizadas a partir de los acuerdos de la Agencia I+D+i con el Banco Centroamericano de Integración Económica (BCIE).
Busca impulsar la transformación de conocimiento científico hacia resultados innovadores (incrementales o radicales) junto a un adoptante que puede ser una empresa o institución pública o privada, de forma tal que los resultados agreguen valor, permitan mejorar la oferta de productos, procesos o servicios, aumentar la productividad, desarrollar potenciales exportaciones, entre otros.
Las otras dos convocatorias de la Agencia I+D+i que cuentan con financiamiento del BCIE son la convocatoria PICT Aplicación Intensiva que está enfocada a Investigación aplicada con alto equipamiento para los cuales exista una demanda social o un mercado potencial y la convocatoria PICT Salto Institucional. Los tres instrumentos realizados a partir del acuerdo de la Agencia con el BCIE implican la movilización de más de 3000 millones de pesos para la promoción científica y tecnológica.